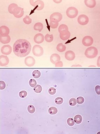

Hematology - First Aid Flashcards
What ingredients contribute to the formation of a purine?
Remember that guanine is the one with a ketone.

What ingredients contribute to the formation of a pyrimidine?
Remember that thymine has a methyl group.

Deamination of what nucleotide will form uracil?
Cytosine
Where in the purine and pyrimidine synthesis pathways do these antineoplastic/antibiotic drugs act: hydroxyurea, 6-mercaptopurine, 5-fluorouracil, methotrexate and trimethoprim?
Hydroxyurea: inhibits ribonucleotide reductase production of deoxynucleotides. 6-MP: blocks Gln-PRPP amidotransferase, preventing PRPP conversion to PRA. 5-FU inhibits thymidylate synthase, decreasing dTMP synthesis. Methotrexate inhibits FH2 reductase, decreasing dTMP synthesis. Trimethoprim only inhibits bacterial FH2 reductase.

A mother brings in her newborn boy complaining of lethargy, irritability and hyperventilation 36 hours after birth. Over the next 24 hours, the lethargy increased and progressed to coma requiring mechanical ventilation. Hemodialysis was started at 5 days and the child died after one week. Two of the mother’s four brothers died shortly after birth from encephalitis. Labs at 36 hours reveal high blood pH, low blood CO2 and low BUN. On day 5 high plasma ammonium, high glutamine, Arg/Citrulline undetectable and high orotic acid in the urine. What is the pathogenesis of this disease?
Ornithine transcarbamoylase (OTC) deficiency. When this enzyme is deficient, the carbamoyl phosphate originally produced for the urea cycle by CPS I cannot continue on in the urea cycle and backs up in the mitochondria. It goes into the cytoplasm to meet with Asp and CPS II takes it to carbamoyl aspartate, then to orotic acid, hence orotic aciduria. Upstream, CPSI isn’t as active from excessive amounts of carbamoyl phosphate and NH4+ builds up. This pushes the equilibrium of glutamine synthetase from glutamate to glutamine and Gln builds up.

A mother brings in her baby complaining of failure to thrive. Labs reveal orotic aciduria, megaloblastic anemia and normal serum ammonia levels. Further testing shows normal B12 and folate levels. How should you treat this child?
Hereditary orotic aciduria is a condition where UMP synthase is lacking and you get build up of orotic acid in the blood. Since they are not making UTP and CTP, they are not making pyrimidine nucleotides and erythropoiesis shuts down in the bone marrow. Giving the child uridine will inhibit CPS II, decrease the amount of orotic acid forming and increase UTP available for use in erythropoiesis.

What is one of the major causes of severe combined immunodeficiency disease (SCID) in kids that is autosomal recessive?
Adenosine deaminase deficiency. This is a defect in the purine salvage pathway that prevents conversion of adenosine to inosine. This results in excess ATP and dATP that feedback inhibits ribonucleotide reductase. This inhibition prevents DNA synthesis and results in a decreased lymphocyte count.

A mother brings in her 2 year old son complaining of retardation, self-mutilation and aggression. Physical exam reveals athetosis in the hands and a swollen big toe. Labs show hyperuricemia. What is most likely causing this child’s condition?
X-linked recessive disorder: Lesch-Nyhan syndrome. This is due to absence of HGPRT. When HGPRT is absent you cannot convert hypoxanthine to IMP or guanine to GMP. This results in excess uric acid production and de novo purine synthesis.

What are the enzymes indicated in the image below?

This is the purine salvage pathway: 1) HGPRT + PRPP is involved in conversion of guanine to GMP. 2) APRT + PRPP is involved in conversion of adenine to AMP. 3) Adenosine deaminase is involved in conversion of adenosine to inosine. 4) Xanthine oxidase is involved in the conversion of hypoxanthine to xanthine and xanthine to uric acid.
What are the three steps involved in polymerase chain reactions (PCR) in the lab?
1) Denaturation: DNA is denatured by heating into 2 separate strands 2) Annealing: while DNA cools, excess pre-made DNA primers anneal to a specific sequence on each strand to be amplified 3) Elongation: heat-stable (Taq) DNA polymerase replicates DNA sequence that follows each primer

Adding a fluorescent labeled DNA or RNA probe that binds to a specific gene site on a chromosome
FISH (Fluorescence in situ hybridization)
Deficiency in what enzyme can cause macrocytic, megaloblastic anemia and is associated with neural tube defects?
Folic acid. It is converted to FH2 by dihydrofolate reductase and then to FH4 by the same enzyme. FH4 is converted to N5,N10-methylene FH4, which is necessary for synthesis of dTMP. If dTMP is absent, DNA and RNA synthesis cannot proceed and erythropoiesis will stall, hence the anemia. N5,N10-methylene FH4 can also be reduced to N5-methyl FH4, which only participates in the reaction with B12 to convert homocysteine to methionine in the cycle that keeps SAM methylated.

What drugs can cause folate deficiency?
Sulfonamides in bacteria and methotrexate in humans. Phenytoin can also cause it.

A 69 year old man presents with fatigue and peripheral neuropathy. Peripheral blood smear shows a macrocytic megaloblastic anemia with hypersegmented neutrophils. Homocysteine and MMA levels are elevated. What are likely causes of this patient’s condition?
He has B12 deficiency, note high MMA and homocysteine levels. Deficiency is usually caused by malabsorption (tropical sprue, enteritis, Diphyllobothrium latum, Crohn’s) or lack of intrinsic factor (pernicious anemia or gastric bypass).

A 69 year old man presents with fatigue and peripheral neuropathy. Peripheral blood smear shows a macrocytic megaloblastic anemia with hypersegmented neutrophils. Homocysteine and MMA levels are elevated. What test would you do on this patient to determine the etiology of his B12 deficiency?
Schilling test: 1) Give a B12 shot to saturate hepatic B12 receptors 2) Give oral radiolabeled B12. If < 10% B12 is found in URINE, it means it was not absorbed and was excreted in the feces. 3) Give oral radiolabeled B12 + intrinsic factor. If urine B12 does not correct it means there is malabsorption. If urine B12 does correct (>10% B12 in urine) it means that he has pernicious anemia.
Among many other reactions, this particular enzyme is involved in the conversion of norepinephrine to epinephrine. Deficiency in what vitamins would inhibit this process?
B12 and Folate. SAM is a universal methyl donor. Once it donates its methyl group it is converted to homocysteine. Homocysteine is converted to methionine by homocysteine methyltransferase, which requires B12. In order to transfer the methyl group, B12 needs to receive it from TF4. Finally, methionine + ATP regenerates SAM.

A mother gives birth to a newborn child and refuses the vitamin K shot. What lab values are likely to be abnormal in this newborn?
Neonates have sterile intestines and cannot synthesize vitamin K because there are no normal flora. If you don’t have vitamin K, the liver cannot catalyze gamma-carboxylation of Glu residues on clotting factors. The child may have an increased PT and aPTT due to lack of clotting factor activity (II, VII, IX, X). Note that they will also be deficient in protein C and S.
A vegan mother of a small child comes in for the child’s wellness check up. You notice areas of hypo and hyperpigmentation on the child’s skin and his belly is swollen. Labs show anemia. What would you expect to see if you examined the child’s liver grossly?
This child has kwashiorkor from protein deficiency. The liver becomes fatty in these kids because there is decreased apolipoprotein synthesis.
What type of malnutrition results in muscle wasting, loss of subcutaneous fat and variable edema in kids?
Marasmus.
What is the rate determining enzyme in de novo pyrimidine synthesis?
Carbamoyl phosphate synthetase II (CPS II)

What is the rate determining enzyme in de novo purine synthesis? What inhibits this enzyme?)
Glutamine-PRPP amidotransferase. Inhibited by AMP, IMP and GMP (excess purines

What is the rate determining enzyme in the urea cycle? What activates this enzyme?
Carbamoyl phosphate synthetase I (CPS I). Activated by N-acetylglutamate.

A 23 year old African American man presents with fatigue after a bout of pneumonia for which he was given antibiotics. Labs show anemia and peripheral blood smear shows bite cells and Heinz bodies. What is causing this guy’s anemia?
He has X-linked G6PD deficiency, the most common human enzyme deficiency, especially in African due to increased resistance to malaria. Sulfonamides, primaquine, anti-Tb drugs and fava beans can cause oxidative stress that increase the workload of G6PD. Inability to produce enough NADPH in RBCs results in inability to reduce glutathione reductase. This results in inability to reduce glutathione peroxidase and accumulation of free radicals that damages the RBC and causes hemolytic anemia. Heinz bodies are oxidized Hbg precipitates in the cytoplasm and bite cells are a consequence of splenic macrophage removal of Heinz bodies from RBCs.

What amino acids are solely glucogenic?
Met, Val, His
What amino acids are solely ketogenic?
Leu, Lys
What amino acids are both glucogenic and ketogenic?
Ile, Phe, Thr, Trp
During periods of starvation you rely heavily on amino acid catabolism to form pyruvate and acetyl CoA that can be used for energy. Excess nitrogen is generated by this process, how do we get rid of it?
*

With all of the extra nitrogen produced in muscle, how does the muscle get that nitrogen to the liver so it can be excreted safe and sound as urea?
*

A 68 year old man with a long history of alcoholism comes to the ED complaining of asterixis, slurred speech, somnolence, blurred vision and vomiting. MRI reveals cerebral edema. How might you treat this man?
Hyperammonemia can be caused by liver disease due to decreased urea production. This results in excess NH4+, depletion of alpha-ketoglutarate and inhibition of the TCA cycle. Glutamate also gets used up which accounts for neurological symptoms. To treat him you would limit dietary protein and possibly give benzoate/phenylbutyrate (sequesters amino acids for excretion) or lactulose (acidifies GI tract to trap NH4+ for excretion).
A mother brings in her newborn boy complaining of lethargy, irritability and hyperventilation 36 hours after birth. Over the next 24 hours, the lethargy increased and progressed to coma requiring mechanical ventilation. Hemodialysis was started at 5 days and the child died after one week. Two of the mother’s four brothers died shortly after birth from encephalitis. Labs at 36 hours reveal high blood pH, low blood CO2 and low BUN. On day 5 high plasma ammonium, high glutamine, Arg/Citrulline undetectable and high orotic acid in the urine. What is the most common cause of the child’s condition?
Ornithine transcarbamoylase deficiency is an X-linked recessive disorder and is the most common urea cycle disorder. Inability to convert carbamoyl phosphate to citrulline causes build up of carbamoyl phosphate and conversion to orotic acid in the pyrimidine synthesis pathway.

A mother brings in her 1 year old baby boy complaining of hyperactivity, purposeless movements, rhythmic rocking and athetosis. He has had two seizures in the past week. History reveals projectile vomiting and pyloric stenosis at birth. Physical exam reveals a musty odor. Labs show phenylacetate, phenyllactate and phenylpyruvate in the urine. What is causing this child’s condition?
Phenylketonuria, an AR disorder. This is due to decreased phenylalanine hydroxylase or decreased tetrahydrobiopterin cofactor. Inability to convert phenylalanine to tyrosine makes Tyr become an essential amino acid and you have to limit Phe intake.

What do you need to do with a pregnant woman who has PKU?
Make sure Phe levels are highly restricted and Tyr is supplemented. If she doesn’t the baby could have microcephaly, mental and growth retardation and congenital heart defects.
A mother brings in her daughter complaining of nystagmus, strabismus, photophobia. Physical exam reveals apigmented irises. What are possible causes of her conditoin?
This patient has albinism. This could be an AR disorder causing absence of tyrosinase. Tyrosinase synthesizes melanin from tyrosine. Albinism is also associated with optic nerve hypoplasia, which is typically X-linked. Another possible cause is that her tyrosine transporters are defective, with decreases in tyrosine leading to decreases in melanin.
Does hyperhomocysteinemia always mean B12 deficiency?
No. It can also indicate folate deficiency and cystathione synthase deficiency (from B6 deficiency or decreased affinity for PLP).

A mother brings in her child complaining of mental retardation and serious CNS defects. Lab reveals sweet smelling urine. Why might an alcoholic begin to exhibit similar symptoms?
The enzyme alpha ketoacid dehydrogenase used in branched chain amino acid catabolism needs thiamine. Alcoholics can become thiamine deficient and build up of the alpha ketoacids causes the urine to smell like maple syrup. Kids can have an AR mutation in alpha-ketoacid dehydrogenase as well.
What vitamins may be deficient in patients with malabsorption syndromes (cystic fibrosis, sprue)?
Fat soluble vitamins: A, D, E, K.
What vitamins may be deficient in patients with dermatitis, glossitis and diarrhea?
B-complex deficiencies: B1 (thiamine:TPP), B2 (riboflavin:FAD,FMN), B3 (niacin:NAD), B5 (pantothenic acid:CoA), B6 (pyridoxine:PLP), B7 (biotin), B9 (folate), B12 (cobalamin)
In addition to the B-complex vitamins, what other vitamin is water soluble?
C
A patient was experiencing night blindness and dry skin a year ago and his wife gave him supplements to try to make him better. He is now complaining of arthralgia, fatigue, headache, skin changes, sore throat and alopecia. What supplement did she likely give him?
Vitamin A (retinol). It is an antioxidant used for visual pigments in retina.
What cancers can be decreased by having proper levels of vitamin A in the diet?
Vitamin A is essential for normal differentiation of epithelial cells into special tissues, this prevents squamous cell carcinoma. It is also used to treat acute myelocytic leukemia (M3).
Why should you think twice about prescribing isotretinoin for severe acne in a pregnant woman?
Excess vitamin A (in isotretinoin to treat wrinkles/acne) can cause cleft palate and cardiac abnormalities.
A patient presents with confusion, ophthalmoplegia, ataxia, confabulation, personality changes, some permanent memory loss and painful tingling in both upper extremities. MRI shows damage to medial dorsal nucleus of the thalamus and mammillary bodies.Physical exam reveals edema, dilated neck veins and symmetrical muscle wasting. What is likely causing this patient’s condition?
He is presenting with Wernicke-Korsakoff syndrome (confusion ophthalmoplegia and ataxia = classic triad), dry beriberi (polyneuritis, muscle wasting) and wet beriberi (edema, dilated cardiomyopathy). This is due to thiamine (B1) deficiency. B1 is needed for glucose breakdown (pyruvate DH and alpha-ketoglutarate DH), when it is deficient, highly aerobic tissues like the brain and heart are affected first. B1 deficiency can arise due to alcoholism or malnutrition.
What enzymes need B1?
Pyruvate DH, alpha-ketoglutarate DH, transketolase (HMP shunt) and branched-chain amino acid DH.
A patient presents with inflammation of the lips, scaling fissures at the corners of the mouth and corneal vascularization. What is likely causing her condition?
Vitamin B2 (riboflavin) deficiency: 2 C’s are cheilosis and corneal vascularization.
A patient presents with glossitis, diarrhea, dementia and dermatitis. What vitamin deficiency commonly presents this way?
B3 (niacin) deficiency: pellagra (3 D’s): diarrhea, dermatitis, dementia.
What are possible causes of B3 deficiency?
B3 (niacin) deficiency can be caused by Hartnup disease w/ decreased Trp absorption, malignant carcinoid syndrome w/ increased Trp metabolism and isoniazid therapy w/ decreases in vitamin B6.
A patient presents with a flushed face after taking several doses of his medication for hyperlipidemia. What medication did he likely take?
Niacin (B3)
Deficiency in what vitamin can present with dermatitis, enteritis, alopecia and adrenal insufficiency?
B5 (pantothenate), an essential component of CoA and fatty acid synthase.
A patient presents with convulsions, hyper irritability, peripheral neuropathy and sideroblastic anemia. What vitamin deficiency could cause her to present this way?
B6 ((pyridoxine) deficiency, among many other things, can cause decreased synthesis of heme and result in sideroblastic anemia with lots of excess iron due to lack of globin chain production.
A patient presents with a rare condition of dermatitis, alopecia and enteritis after use of antibiotics and excessive ingestion of raw eggs. What is most likely causing him to present this way?
B7 (biotin) deficiency is rare, but B7 can be sequestered by avidin in eggs.
What enzymes would be affected by biotin deficiency?
Pyruvate carboxylase, acetyl-CoA carboxylase, propronyl-CoA carboxylase
A patient present with swollen gums, bruising, hemarthrosis, anemia and poor wound healing. He also has a weakened immune response made manifest by recurrent infections. Supplementation of what vitamin will likely help him out?
Vitamin C. It helps w/absorption of Fe by keeping it reduced as Fe2+ and will help correct the anemia. It hydroxylates proline and lysine residues and will strengthen collagen.
A child presents with genu varum deformity in the legs and bone pain. He grows up and struggles with osteomalacia. Supplementation of what vitamin would really help him out? Why?
Vitamin D. D2 (plants) and D3(milk) are stored as 25-OH D3 and activated as 1,25-(OH)2 D3 (calcitrol). Calcitrol increases intestinal absorption of calcium and phosphate, increasing bone mineralization and helps treat Rickets and osteomalacia.
Why do patients with sarcoidosis struggle with hypercalcemia, hypercalciuria, loss of appetite and stupor?
Increased activation of vitamin D by epithelioid macrophages.
Deficiency in what vitamin would be responsible for increased erythrocyte fragility resulting in hemolytic anemia, muscle weakness, posterior column and spinocerebellar tract demyelinization?
Vitamin E. It is an antioxidant that protects RBCs and membrane from free radical damage.
A patient presents with delayed wound healing, hypogonadism, decreased adult hair, dysgeusia and anosmia. Deficiency in what enzyme could cause these symptoms?
Zinc. It is essential for many enzymes and is important in formation of zinc fingers for transcription factor motifs, hence the prepubescent presentation.
What receptor would you target if you wanted to prevent platelets from binding to vWF?
GpIb
What receptor would you target if you wanted to prevent platelets from binding to fibrinogen?
GpIIb/IIIa
Main elements contained in platelet dense granules
ADP, Ca
Main elements contained in platelet alpha granules
vWF, fibrinogen
Who is the universal recipient of RBCs and the universal donor of plasma?
AB. They have no antibodies to either antigen.
Who is the universal donor of RBCs and the universal recipient of plasma?
O. They have no antigens on their surface.
Why give Rho(D) to an Rh- mother prior to delivery of her first child?
This prevents sensitization to an Rh+ baby and will prevent erythroblastosis fetalis in the next fetus that is Rh+
3 stages of formation of the platelet plug
1) vWF bins to exposed collagen on damaged endothelium 2) Platelet GpIb binds vWF, releases ADP/Ca2+, ADP helps platelets adhere to endothelium and induces expression of GpIIb/IIIa 3) Fibrinogen binds GpIIb/IIIa and links platelets together

What are the pro-aggregation factors and anti-aggregation factors that are released in formation of the initial platelet plug?
Pro: TxA2 from platelets decreases flow and increases aggregation. Anti: PGI2 and NO from endothelium increases flow and decreases platelet aggregation.
Know the clotting cascade
*

Why could a newborn baby that was just delivered have similar symptoms as someone who has been on Coumadin or Warfarin for the past two months?
Neither has a functioning vitamin K. The newborn doesn’t have it because neonates lack enteric bacteria that produce vitamin K. People on Warfarin or Coumadin don’t have a functional vitamin K because they inhibit epoxide reductase so vitamin K cannot become reduced to activated factors II, VII, IX, X and proteins C/S.

Why can vWF deficiency present as severe hemophilia A?
vWF complexes w/factor VIII, increasing its half life. When vWF is not complexed w/factor VIII, factor VIII is rapidly degraded.
What factors are inhibited by administration of heparin?
Heparin activates antithrombin III. ATIII inhibits factors II, VII, IX, X, XI and XII
Name 4 things that could cause deficient protein C activity and lead to thrombosis
1) Thrombomodulin does not bind thrombin to activate protein C 2) Protein S is mutated and does not act as a cofactor for protein C 3) Factor V Leiden deficiency renders factor V undegradable by protein C 4) Early Coumadin/Warfarin inhibits production of protein C before the other factors are inhibited.
Bernard-Soulier syndrome
GpIb deficiency = platelets can’t bind to vWF on exposed collagen
Glanzmann’s thrombasthenia. What drug does the same thing this disease does?
GpIIb/IIIa deficiency = platelets can’t link up w/fibrinogen, same as abciximab
How does aspirin help prevent clotting?
Inhibits production of TxA2 from arachidonic acid by COX
Why are clopidoogrel and ticlopidine effective drugs for prevention of thrombosis?
They block ADP receptor activation, inhibiting expression of GpIIb/IIIa receptors. This prevents platelet aggregation by fibrin binding.
Dosing equation for people who need factor VIII replacement
Wt (kg) x desired % x 0.5
Dosing equation for people who need factor IX replacement
Wt (kg) x desired % x 1.2
A mother brings in her child complaining of abdominal colic, foot drop and poor academic performance in school. They live in a very old neighborhood in a home that has never been renovated. Labs reveal a microcytic anemia with basophilic stippling and ringed sideroblasts. What is causing the anemia seen in this child?

This child likely has lead poisoning. Pb2+inhibits ALAD and ferrochelatase, resulting in a build up of protoporphyrin IX and delta-ALA.

A patient presents with a painful abdomen, port wine colored urine, polyneuropathy and psychological disturbances that are precipitated by drugs. You treat him by giving glucose and heme and his symptoms go away. What is causing his condition?
Acute Intermittent Porphyria. This is due to inhibition of PBG deaminase that results in build up of delta-ALA, porphobilinogen and uroporphyrin in the urine.

A patient presents with cutaneous blistering whenever he goes in the sun. He notes tea-colored urine. What is causing his condition?
Porphyria cutanea tarda is caused by uroporphyrinogen decarboxylase deficiency. This results in build up of uroporphyrinogen III that converts to a light sensitive porphyrin in the skin.

What conditions might this patient have?

These are acanthocytes (spur cells). Liver disease and cholesterol dysregulation (abetalipoproteinemia) can cause this.
What conditions might this patient have?

This is basophilic stippling (RNA aggregates). Thalassemia, anemia of chronic disease and lead poisoning can cause this.
What conditions might this patient have?

Sideroblastic anemia is caused by excess iron in mitochondria (X-linked delta-ALAS defect, EtOH, Pb2+ and Isoniazid)
What conditions might this patient have?

Schistocytes appear in DIC, TTP/HUS and traumatic hemolysis (prosthetic heart valves).
What conditions might this patient have?

Spherocytes can come from hereditary spherocytosis or autoimmune hemolysis.
What conditions might this patient have?

Dacrocytes arise from marrow infiltration (myelofibrosis)
What conditions might this patient have?

Target cells arise from HbC, asplenia, liver disease and thalassemia.
What condition might this patient have?

Heinz bodies are associated with G6PD deficiency due to Fe2+ -> Fe3+ after oxidative damage, causing Hgb to precipitate in the RBC cytoplasm. These will eventually become bite cells.
What condition might this patient have?

Howell-Jolly bodies are nuclear remnants in RBCs that arise when people are asplenic or have hyposplenia.
Where are the point mutations in beta-thalassemia found?
Splice sites and promoter regions. This is why, despite being normal, there is decreased beta-chain synthesis.
How do you treat a patient with sideroblastic anemia from alcoholism?
Pyridoxine (B6 is a cofactor for ALAS)
Megaloblastic anemia w/glossitis and hypersegmented neutrophils that does not correct with folate of B12 supplementation? How do you treat?
Orotic aciduria. Deficiency in UMP synthase inhibits the ability to synthesize pyrimidine nucleotides and causes a megaloblastic anemia. Giving uridine monophosphate allows for bypass of the mutated enzyme.
A newborn baby presents with hemolytic anemia. It is determined that the child has rigid RBCs. What is likely causing the anemia?
Pyruvate kinase deficiency = decreased ATP and causes a rigid membrane and extravascular hemolysis.
Labs for paroxysmal nocturnal hemoglobinuria.
CD55,59 negative because GPI anchor for DAF (protects RBC membrane from complement) is deficient and DAF is not attached to the RBC.
HbS mutation
Point mutation in beta chain at position 6 that replaces Glu with Val.
Why do you give hydroxyurea to sickle cell patients?
Increases HbF levels.
Direct Coombs’ test
Anti-Ig Ab added to serum. RBCs agglutinate if RBCs are coated with Ig.
Indirect Coombs’ test
Normal RBCs added to patient’s serum, RBCs agglutinate if serum has anti-RBC surface Ig.
Macroangiopathic anemia
Schistocytes secondary to mechanical destruction (aortic stenosis or prosthetic heart valves)
Antibodies in idiopathic thrombocytopenic purpura
Anti-GpIIb/IIIa, spleen eats them up
Treatment for vWF disease
DDAVP (desmopressin) releases stored vWF from endothelium
What factors remain activated in patients with protein C or S deficiency?
V and VIII
Components of cryoprecipitate
Factors I, VIII and XIII. vWF and fibronectin.
t(9;22)
Philadelphia chromosome. Bcr-abl fusion.
t(8;14)
Burkitt’s c-myc
t(11;14)
Mantle, cyclin D1 (bcl1)
t(14;18)
Follicular, bcl2
t(15;17)
M3 AML, retinoic acid receptor
JAK2 mutations
Polycythemia vera (RBCs), essential thrombocytosis (megakaryocytes), myelofibrosis
A pregnant woman presents with a DVT that dislodged and cause a PE. Oxygen deprivation caused an MI. What drug would you give her? What lab value do you track to see if your drug is working?
Heparin. It does not cross the placenta and activated antithrombin III, decreasing levels of factors IIa and Xa. Track PTT for progress.
A pregnant woman presents with a DVT that dislodged and cause a PE. Oxygen deprivation caused an MI. You give her heparin and she develops thrombosis and thrombocytopenia. What happened?
HIT: IgG antibodies against heparin bound to PF4 form a complex and activate platelets.
A patient presents who has a history of strokes, STEMI and venous thromboemboli. She is not pregnant. What drug do you give to prophylax for her previous conditions? How do you track her progress with this drug?
Warfarin (Coumadin). It crosses the placenta, but she is not pregnant so you can use it. It interferes with gamma-carboxylation of factors II, VII, IX, X, protein C and protein S in the liver. You follow the PT to track drug efficacy.
How do you rapidly reverse the effects of a warfarin overdose?
FFP. Vitamin K can be given but it takes too long to resynthesize the appropriate clotting factors.
Where in the cell cycle do vinca alkaloids, paclitaxel, MTX, 5-FU, Ara C, 6-MP, 6-TG, Hydroxyurea, bleomycin, L-asparaginase and etoposide work?

*

What antineoplastic drugs inhibit nucleotide synthesis?
Methotrexate (blocks dihydrofolate reductase) & 5-FU (blocks thymidylate synthase) inhibit thymidine synthesis. 6-MP inhibits purine synthesis (inhibits glutamine-PRPP amidotransferase)

What antineoplastic drugs cross-link DNA?
Alkylating agents and cisplatin
What antineoplastic drugs intercalate into DNA?
Dactinomycin, doxorubicin
What antineoplastic drug inhibits topoisomerase II, thereby increasing DNA degradation?
Etoposide
What antineoplastic drugs inhibit microtubule formation?
Vinca alkaloids
What antineoplastic drug inhibits microtubule disassembly?
Paclitaxel
When do you use leucovorin?
Rescue therapy from myelosuppression by methotrexate
What cancers do you use MTX to treat?
Leukemias and lymphomas
When do you use thymidine?
Rescue therapy from myelosuppression by 5-FU
What cancers do you use azathioprine, 6-MP and 6-TG to treat?
Leukemias
What cancers do you use dactinomycin to treat?
Childhood tumors (Wilms’, Ewing’s, rhabdomyosarcoma)
What chemotherapy drugs have an increased risk for cardiotoxicity and cause nausea and vomiting due to strippage of GI tract and CTZ binding?
Doxorubicin and daunorubicin. They noncovalently intercalate into DNA and generate free radicals. Cardiac tissue has a hard time dealing with free radicals.
What cancers do you use doxorubicin and daunorubicin for treatment?
Leukemias and lymphomas.
How does bleomycin work?
Generates free radicals that for DNA strand breaks.
What cancers do you treat with bleomycin?
Hodgkins lymphoma
What chemotherapy drug is used to treat leukemia and lymphomas that can cause hemorrhagic cystitis? How do you prevent this?
Cyclophosphamide covalently cross links at guanine’s N-7. You can prevent hemorrhagic cystitis with mesna, which binds the toxic metabolite.
What chemotherapy drugs are especially good for CNS tumors because they can cross the BBB?
Nitrosoureas (carmustine, lomustine, semustine and streptozocin)
What chemotherapy drug is used for CML and ablation of bone marrow before transplantation?
Busulfan, it cross-links DNA.
Chemotherapy drugs that can cause peripheral neuropathy and SIADH.
Vincristine and vinblastine bind tubulin in M phase and block microtubule polymerization so mitotic spindle can’t form. Neurons need tubulin for synaptic transmission.
Chemotherapy drugs that you never give to someone on vincristine or vinblastine.
Paclitaxel and other taxols.
What drug used for sickle cell disease can also be used for CML?
Hydroxyurea. It inhibits ribonucleotide reductase and decreases DNA synthesis.
What chemotherapy drug is used in CLL and N-H lymphoma that can cause Cushing’s syndrome?
Prednisone. It triggers leukocyte apoptosis.
What chemotherapy drug is used specifically to target the bcr-abl translocation in CML?
Imatinib (Gleevec) inhibits the mutated tyrosine kinase.
Chemotherapy monoclonal antibody used for most B-cell neoplasms?
Rituximab (anti-CD20 Ab)
Monoclonal antibody that prevents angiogenic effects
Bevacizumab, anti-VEGF Ab.
What are the common chemotoxicities?

Cisplatin/Carboplatin = acoustic nerve and kidney damage. Bleomycin/busulfan = pulmonary fibrosis. Vincristine = peripheral neuropathy. Doxorubicin/trastuzumab = cardiotoxicity. Cyclophosphamide = hemorrhagic cystitis. 5-FU/6-MP/MTX = myelosuppression.
What monoclonal antibody is used to treat HER-2 positive breast cancers?
Trastuzumab. Inhibits the tyrosine kinase.
What drug will increase 6-MP, 6-TG myelosuppression?
Allopurinol. These drugs are metabolized by xanthine oxidase, allopurinol inhibits xanthine oxidase.
Chemotherapy drug that causes photosensitivity
5-FU
Chemotherapy drugs that cause alopecia
Vincristine, daunorubicin
Chemotherapy drug that causes hypersensitivity due to E. coli origin
L-asparaginase